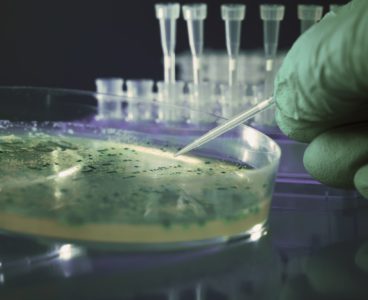

Store swabs in a refrigerator at no more than 46 degrees F. Avoid leaving swabs at room temperature for more than 20 minutes. ATP systems may need to conduct a “self-test” for about 60 seconds when first turned on. Avoid using the unit until it has finished performing this test. For flat surfaces, swab a 4-in. x 4-in.…
Avoiding the “Killer Defect”
A cleanroom is a controlled environment specially designed to keep the concentration of contaminants to a minimum. So we are all on the same page, contamination can be defined as a process or an action that causes surfaces, instruments, or equipment to become soiled with contaminating substances. These substances can include pathogens (germs, bacteria, toxins), threads and fibers, fluids, and soils, among other…
Cleanroom Tip: Safety Checklist for Cleaning
Contract cleaners should know that just wearing gloves and, hopefully, goggles is not enough to ensure worker safety. There are several other items that should be worn, are required to be worn by OSHA regulations, or stored nearby in case of an emergency. Refer to the following Building and Maintenance Safety Checklist, to further enhance…